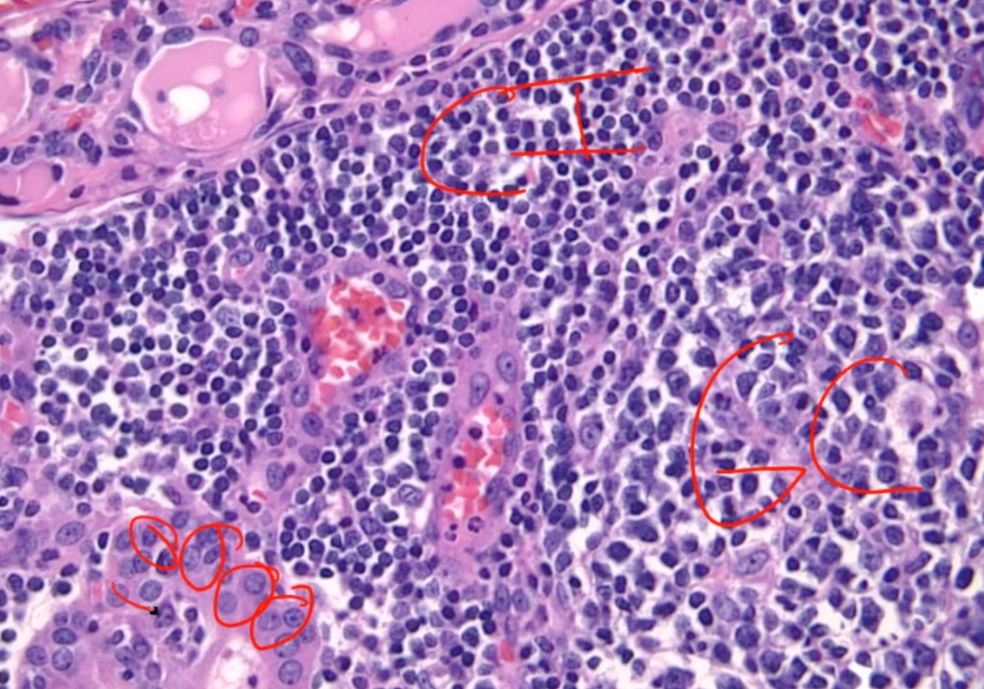

02 Thyroid Disorders
Overview
_Thyroid disorders are divided into three general groups:
Hypothyroidism
Hyperthyroidism
Thyroiditis..
Hypothyroidism Causes
_Major etiologies Include:
Iodine deficiency
Iodine excess
Congenital hypothyroidism
Amiodarone, lithium
Thyroiditis
Hashimoto thyroiditis (#1 cause with sufficient dietary iodine)
Subacute thyroiditis
Riedel's
Surgical thyroid removal or thyroid ablation (surgical or I-131 radiation)..
_Octreotide inhibits TSH secretion..
_Cholestyramine inhibits thyroid hormone absorption in gut..
Iodine Excess
_..


Amiodarone
_..


Iatrogenic hypothyroidism
_..

Child Hypothyroidism
_Term used to describe arrested physical and mental development due to congenital hypothyroidism. Testing of all newborns for hypothyroidism (elevated TSH) is standard of care, because mental retardation can be minimized when thyroid hormone is administered during the neonatal period.,
Most common treatable cause of mental retardation
_T4/TSH newborn screening. Heel-stick blood specimens..
_Babies with low thyroid hormones are asymptomatic because maternal T3/T4 cross placenta..
_Most commonly caused by thyroid dysgenesis in the US. This may be secondary to maternal hypothyroidism, thyroid agenesis, iodine deficiency, or dyshormonogenic goiter.
.,
_Symptoms:

Mental retardation from lack of CNS maturation.
Coarse facial features, including wide-set eyes and a broad flat nose may be present in an infant with congenital hypothyroidism. Infants are also described as having a characteristic "puffy face".
Congenital hypothyroidism may present with a hoarse cry, weak cough, and slow respiratory effort
Prolonged neonatal (physiologic) jaundice may result from congenital hypothyroidism.
The arrest of physical development associated with congenital hypothyroidism may result in enlarged fontanelles, delayed dentition and retarded bone age.
An infant with congenital hypothyroidism may have dry skin and scarce lanugo (unpigmented downy hair), as well as a pale body with mottled cool extremities..
Hypothyroidism Symptoms
_Describes a condition in which the thyroid gland does not produce enough thyroid hormone. Primary hypothyroidism accounts for >95% of cases, and describes a group of abnormalities related to the thyroid gland itself..
_Results in signs and symptoms that reflect the abnormal function of many organ systems. Generally metabolism slows down:

.,
CV Symptoms
_Include:
Peripheral vasoconstriction to maintain body heat, which leads to cool, pale, dry skin
Decreased synthesis of cardiac β1 receptors, which leads to
Bradycardia
Decreased contractility and decreased stroke volume (decreased pulse pressure)
Decreased cardiac output, which decreases exercise capacity and dyspnea on exertion
Blunted EKG voltages
Accelerated atherogenesis, due to increased total cholesterol and LDL levels (LDL receptor expression regulated by thyroid hormone).,
CNS Symptoms
_Include:
Slow deep tendon reflexes, with a prolonged relaxation phase
Fatigue and lethargy
Mental slowness
Perinatal mental retardation.,
MSK Symptoms
_Include weakness, cramps, myalgias and increased serum creatinine kinase.,
Dermatologic symptoms
_Include:
Coarse, brittle hair and nails
Yellow/orange, dry skin
Facial and periorbital myxedema
swelling of the skin and underlying tissue gives the skin a 'waxy' appearance.,
GI Symptoms
_Include decreased GI motility, which manifests as constipation.,
Endocrine symptoms
_Include hyperprolactinemia (if primary or secondary hypothyroidism). The decrease in T3 and T4 production increases TRH, which stimulates prolactin release.,
Metabolic Symptoms
_Include:
Decreased basal metabolic rate, resulting in a decreased O2 consumption which effectively reduces respiratory rate
Positive nitrogen balance (anabolic), which leads to weight gain
Decreased heat production, which decreases sweating and results in cold intolerance
Growth retardation.,
Myxedema
_Aka thyroid dermopathy.,
_Dermatologic conditions association with hypothyroidism. Symptoms include:
Non-pitting edema of the skin
Usually facial or periorbital swelling
Deepening of voice (larynx swelling) and large tongue

.,
_Hyaluronic acid is a glycosaminoglycan, a mucopolysaccharide, in the dermis. It is an osmotic agent that draws water into the interstitium, resulting in swelling. In longterm hypothyroid state, hyaluronic acid deposits in the dermis.,
Pretibial myxedema
_Special form of myxedema over shin. Localized dermopathy characterized by thickening of skin overlying non-pitting edema.,
_Occur in hyperthyroid states (notably Graves disease).,
Myxedema coma
_A serious complication of hypothyroidism, which generally occurs in patients with long-standing hypothyroidism that have not been properly treated. Is the only emergent hypothyroid condition.,
_Symptoms are coma that includes:
Hypothermia
Hypoventilation
Hypotension.,
_Can have a spontaneous onset, or it can be precipitated by:
Cold exposure
Infections
Drugs (CNS depressants)
Hypoxia.,
_Treatment include:
Respiratory support
Intravenous levothyroxine (see below)
Cortisol
warmth, fluids, hypertonic saline
The use of T4 alone, combined T4 and T3, or T3 alone is controversial. Deiodinase conversion of T4 to the active hormone T3 is often reduced in these patients, advising T3 administration. However, T3's more immediate action and short half-life may be more likely to cause arrhythmias (particularly with compromised myocardial function).,
Hyponatremia
_..

Hypothyroidism Treatment
_Usually just gives T4..

Hyperthyroidism Causes
_Aka thyrotoxicosis.,
_The most common cause is Graves disease. Other causes:
Toxic multinodular goiter
amiodarone
iodine load
early thyroiditis.,
Graves
_Females are affected 10x more frequently than males, with a peak incidence between age 20-40.,
_Is caused by a type II hypersensitivity reaction.,
_A decrease in self-tolerance to thyroid auto-antigens leads to the production of autoantibodies.
Thyroid-stimulating immunoglobulin (TSI) is an IgG that binds and activates TSH receptor, mimicking the action of TSH. TSI is relatively specific the disease.,
_TSI, Anti-thyroglobulin, and anti-thyroid peroxidase antibodies are often present.,
_Hyperthyroidism results from continuous stimulation of the thyroid gland by IgG autoantibodies. This stimulation leads to diffuse, symmetrical, nontender and hyperfunctional enlargement of the thyroid (aka diffuse goiter)..
_Associated with HLA-DR3 and HLA-B8.,
_Eye symptoms is characterized by:
exophthalmos (bulging eyes)
proptosis (protrusion of eye)
periorbital edema
impairment of the extraocular muscles
No ocular symptoms
.,
Pretibial myxedema
_Infiltrative dermopathy. A scaly thickening and induration of the skin overlying the shins with nonpitting edema, results from TSH receptor stimulation on dermal fibroblasts. This only occurs in 1-2% of patients.,
_Histologic findings include:
Diffuse hypertrophy and hyperplasia of thyroid follicular epithelial cells
Colloid appears pale with scalloped (moth-eaten) margins due to increased colloid absorption.
Lymphocytic infiltrate leads to germinal centers in the thyroid (more commonly seen in Hashimoto thyroiditis). **


.,
_The most common treatment in the U.S. is radioactive iodine (131I)..

_Graves ophthalmopathy follows its own course..

Steroids for inflammation because of lymphocytes.
Thyroid Storm
_A life threatening complication of Graves disease. It describes an abrupt-onset of severe thyrotoxicosis.,
_Is most likely induced by an acute massive elevation in catecholamine levels in patients with preexistng hyperthyroid disease, as seen in situations of acute stress including infection, surgery, trauma.,
_Most commonly seen in patients with Graves disease, as well as other hyperthyroid disorders such as toxic multinodular goiter.,
_Patients will present with:
High fever
Delirium
Tachycardia with death from arrhythmia (out of proportion to fever)
Diarrhea
Vomiting
Coma.,
_Typical lab results include:
Decreased TSH
Increased T3 and T4
Elevated liver enzymes
Hyperglycemia from catecholamines and thyroid hormone
Hypercalcemia from bone turnover.,
_Treated with the 4P's and bile acid resins:
Propranolol (propranolol or esmolol)
Propylthiouracil (PTU)
Prednisone (and other corticosteroids)
Potassium iodide compounds (e.g. Lugol iodine)
Bile acid resins (e.g. cholestyramine)

Adrenal insufficiency from thyroid storm depleting cortisone.,
_Complications include:
Tachyarrhythmias (notably atrial fibrillation and ventricular fibrillation) which are the most common cause of death in patients with thyroid storm
Shock (heart failure, diarrhea/vomiting-induced volume depletion)
Coma.,
Goitrogens
_Substance that disrupts the production of thyroid hormones by interfering with iodine uptake in the thyroid gland. This triggers the pituitary to release TSH, which then promotes the growth of thyroid tissue, eventually leading to goiter.,
_Examples include:
Iodine, most common
Lithium, used in psychiatry, inhibit thyroid hormone release
Certain foods (cassava, plant; millet, grass)
Many cruciferous vegetables are goitrogens (broccoli, brussel sprouts).,
Goiter
_An enlarged thyroid gland, which has undergone hyperplasia in response to excessive stimulation of TSH receptors.,
_There are three types of goiters:
Simple
Multinodular
Dyshormonogenetic..
_A fixed, painless and hard (rock-like) goiter.,
_Autoantibodies stimulate TSH receptors, resulting in the formation of a diffuse goiter.,
Simple goiter
_Occurs when the body is unable to produce sufficient thyroid hormone, and the thyroid gland undergoes hyperplasia in response. In many cases the etiology is unknown, but it may be caused by a lack of dietary iodine or intrinsic thyroid hormone production defects.,
Simple goiter: 
_Patients with iodine deficiency goiters are most commonly euthyroid. Goitrous hypo- and hyperthyroidism may also be seen, but this is less common. See endemic goiter..
Multinodular goiter
_Describes an enlarged thyroid gland with multiple nodules, typically due to relative iodine deficiency. Patients are usually euthyroid.,
Multilodular goiter 
Toxic multinodular goiter
_Toxic adenomas: 1 nodule Toxic multinodular goiter: multiple nodules..
_Contains focal patches of hyperfunctioning follicular cells that function independently of thyroid stimulating hormone (TSH) due to a mutation of the TSH receptor., The term 'toxic' does not mean malignancy, rather it refers to the hyperthyroidism (thyrotoxicosis) that results from these self-sufficient nodules.
_As a result of the autonomously functioning thyroid nodules, the release of T3 and T4 is increased resulting in hyperthyroidism.,
_Treatment is surgery or radioactive iodine to differentiate between benign nodules and cancer..
Endemic goiter and iodine deficiency
_Simple/multinodular goiter caused by dietary iodine deficiency; The most common cause of hypothyroidism worldwide.,
_Commonly found in mountainous areas (iodine depleted by run-off).,
_Constant elevation of TSH result in enlarged thyroid..

Dyshormonogenetic
_Genetically-determined thyroid hyperplasia that result from enzyme defects in thyroid hormone synthesis, most commonly thyroid peroxidase. These deficiencies are a cause of congenital hypothyroidism (cretinism).,
Jod-Basedow
_Describes iodine-induced hyperthyroidism. It arises in two settings:
Administration of iodine to a patient with an iodine deficiency goiter (e.g. patient with endemic goiter relocates to iodine-abundant geographical location)
Patients with toxic adnomas, hot nodules, or Graves disease:
Drugs with high iodine content
Exectorants (potassium iodide)
CT contrast dyes
Amiodarone.,
Hyperthyroidism symptoms
_Results in signs and symptoms that reflect the abnormal function of many organ systems. These include:

.,
CV Symptoms
_Include:
Peripheral vasodilation to get rid of heat which leads to warm, flushed skin
Increased synthesis of cardiac β1 receptors which leads to:
Increased heart rate (sinus tachycardia)
Increased contractility and increased stroke volume (increased pulse pressure)
Increased cardiac output
Cardiomegaly, systolic hypertension, high-output heart failure
Hypercalcemia-induced EKG changes (due to increased bone turnover),
Arrhythmias (especially atrial fibrillation) secondary to increased heart rate and/or cardiomegaly.,
CNS Symptoms
_Include an increased sympathetic nervous system tone. This leads to:
Fine tremor (hands)
Anxiety
Insomnia
Emotional lability
Inability to concentrate
Fast deep tendon reflexes.,
Eye Symptoms
_Are secondary to the increase of sympathetic nervous system tone. Overstimulation of the superior tarsal muscle (elevate the upper eyelid) leads to a wide-eyed staring gaze and lid lag
TSI & other autoantibodies cross-react with and stimulate several tissues in the body containing TSH receptors, including:
Thyroid
Retro-orbital fibroblasts (activated by T lymphocyte)
Dermal fibroblasts (activated by T lymphocyte)
When stimulated, TSH receptors on orbital pre-adipocyte fibroblasts synthesize hydrophilic glycosaminoglycans (notably hyaluronic acid and chondroitin sulfate). The accumulation of glycosaminoglycans, infiltration of fat and T cells in the retro-orbital space, and edema of the extraocular muscles all lead to exophthalmos (proptosis). This occurs in 50% of patients..
_NOTE that true thyroid ophthalmopathy with exophthalmos (proptosis) is only seen in Graves disease..
GI Symptoms
_Increasing GI motility, which leads to malabsorption and diarrhea.,
Endocrine Symptoms
_Include:
Increased bone turnover, leading to osteoporosis and an increased risk of fractures
Oligomenorrhea.,
Metabolic Symptoms
_Include:
Increased basal metabolic rate, resulting in increased O2 consumption which effectively
increases respiratory rate (tachypnea)
Weight loss, despite an increased appetite
Negative nitrogen balance (catabolic), which can lead to thyroid myopathy (proximal muscle weakness and decreased muscle mass)
Increased heat production and sweating, leading to heat intolerance.,
Hyperthyroidism treatments
_Treatment includes:
β-blockers (propanolol)
Thioamides
High-dose iodide
Radioactive iodine (131I).,
B-Blockers
_Are indicated to control the symptoms of increased sympathetic nervous system tone. Furthermore, propranolol decreases peripheral conversion of T4 to T3 by interfering with the activity of 5'-deiodinase, producing a net decrease in thyroid hormone actions at target tissues.,
Thioamides
_Include PTU and methimazole.,
_Thioamides may induce remission by blocking new thyroid hormone production via inhibition of the organification and coupling steps of thyroid hormone synthesis. In addition, PTU (but not methimazole) also inhibits peripheral conversion of T4 to T3..
_SE include:

.,
Methimazole
_A teratogen.,
_Use PTU in pregnancy, especially 1st trimester. Methimazole better for long term because less hepatotoxicity also good in breastfeeding (not found in breast milk)..
High-dose iodide
_Blocks the release of T4 and T3 into circulation and transiently inhibits thyroid hormone synthesis by blocking the organification step (Wolff-Chaikoff effect).,
Iodine 131I
_Different from the 123I used in imaging studies. Becomes concentrated in the thyroid gland. This leads to ablation of follicular cells, and decreases thyroid function..
Thyroiditis
_Thyroiditis can cause either hypothyroidism or hyperthyroidism:
Early state: Inflammation causes more secretion of thyroid hormones and thus hyperthyroidism
Late state: Eventually, thyroid is burned out and produces less thyroid hormones, thus hypothyroidism..
Hashimoto thyroiditis
_The most common cause of hypothyroidism in iodine-sufficient regions, or developed countries.,
_Aka chronic autoimmune thyroiditis.,
_Histologically, defined by:
Lymphocytic infiltrate (germinal centers)
Atrophic thyroid follices lined by Hürthle cells (pink epithelial cells).,
Chronic inflammation, germinal centers and Hurthle cells:

_Because thyroid follicles are normally lined by low cuboidal epithelium, this is also known as Hürthle cell metaplasia.,
_Caused by autoimmune-mediated destruction of the thyroid gland. Thyroid cell death results from a failure of self-tolerance to thyroid auto-antigens:
CD8+ T-cell mediated cell death
Activated TH1 cells release IFN-γ that recruits and activates macrophages, which release inflammatory mediators that inflict follicle damage.
Anti-thyroid autoantibodies (anti-Tg and anti-TPO) from B cells lead to complement activation and antibody-dependent cell-mediated cytotoxicity.,
_Include anti-thyroglobulin antibodies and anti-thyroid peroxidase (TPO) antibodies (markers of thyroid damage). But no TSI. Note that TPO was formerly known as microsomal antigen.,
_Is associated with HLA DR3 and DR5.,
_Presents as a nontender thyroid, which often becomes diffusely enlarged. The development of hypothyroidism (and resultant symptoms) is insidious, most commonly in women age 30-50.,
Early in the course of Hashimoto thyroidis, hyperthyroidism may occur as thyroid follicles rupture, causing thyrotoxicosis.
_Increased risk of developing: Other autoimmune diseases, for example:
Primary thyroid lymphoma, particularly B-cell non-Hodgkin lymphomas (extranodal marginal zone lymphomas of mucosa-associated lymphoid tissue [MALT] type).
Type 1 Diabetes Mellitus
Systemic Lupus Erythematosus
Sjögren’s syndrome
Myasthenia Gravis
Pernicious anemia.,
_The treatment for hypothyroidism associated with Hashimoto thyroiditis is levothyroxine..
Acute suppurative thyroiditis
_Often occurs secondary to bacterial infection, such as with Staphylococcus aureus.,
_Symptoms include:
Fever
Painful thyroid
Painful cervical lymphadenopathy
Gland destruction leads to an initial thyrotoxicosis, with labs including:
Increased serum T4
Decreased serum TSH
Decreased I-123 uptake.,
_Because of a frequent bacterial etiology, this condition is commonly treated with antibiotics.,
Subacute granulomatous thyroiditis
_ aka DeQuervain thyroiditis.,
_Occus in young female.,
_Can be caused by mumps or coxsackievirus.,
_Presents as a tender thyroid and is the most common cause of thyroid pain. This is in contrast to both Hashimoto thyroiditis and Riedel thyroiditis, which present without thyroid pain.
Early phase can manifest as hyperthyroidism, as the damaged gland spills T4. Over time, it can progress to a state of hypothyroidism
No lymphadenopathy, which is a different physical exam finding than with acute thyroiditis
Preceded by a flu-like illness including:
Sore throat and fever
Jaw pain
Tender thyroid
Markedly elevated erythrocyte sedimentation rate.,
_On histology, a lymphocytic infiltrate with multinucleated giant cells surround fragments of colloid.

.,Subacute granulomatous thyroiditis. Note the giant cells, inflammatory cells and destruction of the thyroid follicules.
_The treatment is aspirin. In severe disease, cortisol may supplement this treatment. Thyroid symptoms is mild and resolve in a few weeks.,
Subacute lymphocytic (painless) thyroiditis
_Aka painless thyroiditis.,
_Variant of Hashimoto's where lymphocytes infiltrate the thyroid gland.,
_Presents as a nontender thyroid and transient hyperthyroidism followed sometimes by hypothyroidism:
Transient hyperthyroidism: can look like Grave's without eye/skin findings (serum TSI not elevated)
Hypothyroidism: can look like Hashimoto's.,
_Occuring most commonly in postpartum women.,
_On histology, appears with lymphocytic infiltrate and prominent germinal follicles. Hürthle cell metaplasia is not prominent (versus Hashimoto thyroiditis, in which Hürthle cell metaplasia is a prominent feature).
.,Lymphcytic inflitrate seen in subacute lymphocytic thyroiditis.
_Usually self limited (weeks). Roughly one third of patients develop hypothyroidism within 10 years.,
Riedel Thyoiditis
_Occurs when fibrous tissue (collagen) replaces thyroid parenchyma, causing the patient to be hypothyroid.
.,Riedel Thyroiditis. Note how the thyroid gland parenchyma has been overrun by fibrous tissue.
_The thyroid gland is:
Fixed
'Hard as wood' or 'rock-like'
Painless
Often extends beyond the thyroid:
parathyroid gland: hypoparathyroidism
recurrent laryngeal nerves: hoarseness
trachea compression: difficulty breathing.,
_Classified as an IgG4-related systemic disease, which is characterized by:
Lymphoplasmacytic tissue infiltrates with abundant IgG4-producing plasma cells
Storiform fibrosis
Elevated serum IgG4 concentrations.,
_Fibrosis extends beyond the thyroid capsule and into the surrounding tissue in both Riedel thyroiditis and anaplastic carcinoma. A patient with Riedel thyroiditis will be younger (average age 40) than a patient with anaplastic carcinoma, and malignant cells will be absent on biopsy..
IgG4 related diseases
_Include:
Autoimmune pancreatitis
Non-infectious aortitis
Retroperitoneal & mediastinal fibrosis
Riedel thyroiditis.,
Thyroid Cancer
Thyroid is bloody organ. Do not cut open

..
_Types:
Papillary carcinoma: most common
Follicular carcinoma
Medullary Carcinoma
Anaplastic Carcinoma.,
Follicular Adenoma


.,
Looks like follicles in tumor with capsule around it.
Follicular Carcinoma



.,
_Spread hematogenously.,
Cancers spreading hematogenously
_Cancers:
RCC
Hepatocellular carcinoma
Follicular carcinoma
Choriocarcinoma.,
_FNA only examines cells and not capsules, thus cannot make distinction between the two.,
Papillary Carcinoma
association with protooncogene BRAF, serine/threonine kinase.,
_Cause:
acne radiation
.,
_Histology:
Orphan Annie eye nuclei: no nuclei
Nuclear grooves: line through nucleus
Psamomma bodies





.,
_Spread to cervical but excellent prognosis.,
Medullary Carcinoma

flushing and diarrhea.,
_Histology:
malignant cells in amyloid stroma

.,
_Association:
.,
_Treated with surgery because does not take up iodine.,
Anaplastic Carcinoma
.,
.,
_Similar to Riedel
.,
_Histology shows undifferentiated cells that look like nothing else
.,
Misc
Amiodarone
_Can cause both hypo and hyperthyroidism:
Iodine excess and inhibition of 5-deiodinase causes hypothyroidism
Can cause hyperthyroidism in patients with thyroid disease and destructive thyroiditis in patients with no thyroid disease..


Iodine
_can cause both hypo and hyperthyroidism:
Chronic deficiency causes hypothyroidism and goiter because of constant TSH elevation stimulating thyroid.
Chronic excess causes hypothyroidism via Wolff-Chaikoff effect.
In patients with toxic adenomas and endemic goiters, a load can cause hyperthyroidism via Jod-Basedow effect..

Oligomenorrhea
_In hypOthyroidism-- you have decreased t3 and decreased t4. This causes TRH to be INCREASED ( trh from hypothalmus)--> We know that TRH stimulates PROLACTIN and hyperprolactinemia cuases decreased LH/FSH --> amenorrhea..
_HypERthyroidism can also cause amenorrhea. The mechanism behind this involves SHBG regulation ( produced in liver). So, hyperthyroidism leads to Increased production of SHBG-- this leads to decreased amount of free estrogen --> decreased chances that you will have an LH peak and therefore AMENORRHEA..
Labs
Primary thyroid dysfunction are caused by thyroid dysfunction (most common)
Secondary thyroid dysfunction are caused by pituitary dysfunction
Tertiary are caused by hypothalamic dysfunction..
Primary hypo/hyperthyroidism labs
_TSH is opposite thyroid hormone:
Hypothyroidism = high TSH and low T3/T4
Hyperthyroidism = low TSH and high T3/T4.,
Central hypo/hyperthyroidism labs
_Aka secondary or tertiary thyroid dysfunction.,
_TSH parallels thyroid hormones:
Hypothyroidism = low TSH and low T3/T4
Hyperthyroidism = high TSH and high T3/T4.,
_Causes:

In the rare case that a patient has secondary hyperthyroidism due to a TSH-secreting pituitary adenoma, inject TRH and look for an increase in TSH..
_Best initial test because it tests at tissue level, and doesn't flucuate like T3/T4, which test at serum level. TSH is most sensitive test..
Tertiary hypothyroidism
_TSH levels will be normal/low-normal, but in rare cases may be elevated. For this reason, TSH and free thyroxine are examined concurrently when central hypothyroidism is expected..
Reverse T3
_Usually parallels T4 levels..
_Used in Euthyroid sick syndrome.,
Critically ill patient will have low TSH and low T3/T4 that looks like central hypothyroidism
rT3 rises in critical illness due to impaired clearance
Checking rT3 in critically ill patient will tell whether patient has central hypothyroidism or sick euthyroid syndrome.
T3 Toxicosis
_An increase in serum T3 with low or normal serum T4. Can be seen in any condition that causes hyperthyroidism, and the treatment is the same as for hyperthyroidism.,
_Other lab findings include:
increased bone turnover, and therefore an increase in serum calcium (hypercalcemia),
increased glycogenolysis, and therefore an increase in serum glucose (hyperglycemia), and
increased low densitiy lipoprotein (LDL) receptor synthesis, and therefore a decrease in serum cholesterol (hypocholesterolemia)..,
123I
Increased diffused uptake: Graves
Decreased diffused uptake: Hashimoto, thyroiditis, exogenous thyroid
Hot nodules: Toxic multinodular goiter
Cold nodules: Adenoma or cancer, thus FNA needed
patches of multinodular goiter 
Excess thyroid hormone negatively feeds back on the pituitary, leading to decreased TSH. This decrease in thyroid activity manifests as decreased 123I uptake, with thyroid gland atrophy..
Last updated